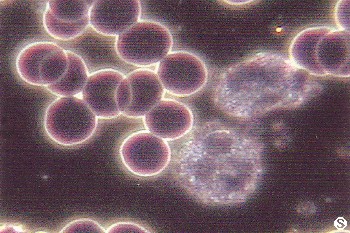
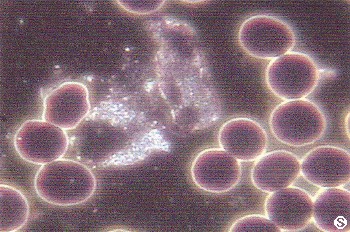

Serenelli's Cancer Experience diary...
Serenelli's Cancer Experience diary...
Live Cell Test - 23 Dec, 2003 & 6 Jan, 2004 Back to index | |
Stephen (23 Dec, 2003) | Eileen (6 Jan, 2004) |
|---|---|

|

|

|

|

|

|

|

|

|
|

|
|

|

|

|

|
Copyright © 1993 Serenelli Desktop Publishing. All Rights Reserved.